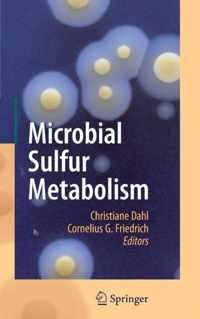
Microbial Sulfur Metabolism

rode sulfur online kopen
Ben je op zoek naar rode sulfur? Bekijk onze boeken selectie en zie direct bij welke webshop je rode sulfur online kan kopen. Ga je voor een ebook of paperback van rode sulfur. Zoek ook naar accesoires voor rode sulfur. Zo ben je er helemaal klaar voor. Ontdek ook andere producten en koop vandaag nog je rode sulfur met korting of in de aanbieding. Alles voor veel leesplezier!
Rode sulfur. Robert Bosnak, Paperback
Vergelijkbare producten zoals Rode sulfur. Robert Bosnak, Paperback
Rode sulfur (Printing-On-Demand). Robert Bosnak, Paperback
Vergelijkbare producten zoals Rode sulfur (Printing-On-Demand). Robert Bosnak, Paperback
Elemental Sulfur and Sulfur-Rich Compounds I
Elemental Sulfur and Sulfur-Rich Compounds I is een boek van Springer;
Vergelijkbare producten zoals Elemental Sulfur and Sulfur-Rich Compounds I
Elemental Sulfur and Sulfur-Rich Compounds I
Elemental Sulfur and Sulfur-Rich Compounds I is een boek van Ralf Steudel;
Vergelijkbare producten zoals Elemental Sulfur and Sulfur-Rich Compounds I
Sulfur Assimilation and Abiotic Stress in Plants
The assimilation of sulfur in higher plants and its reduction in metabolically important sulfur compounds are crucial factors determining;
Vergelijkbare producten zoals Sulfur Assimilation and Abiotic Stress in Plants
Organic Sulfur Chemistry
This volume contains fundamental knowledge regarding the structure and mechanisms of organic sulfur chemistry. Topics include sulfur;
Vergelijkbare producten zoals Organic Sulfur Chemistry
Sulfur-Containing Polymers: From Synthesis to Functional Materials
A must-have resource to the booming field of sulfur-containing polymers Sulfur-Containing Polymers is a state-of-the-art text that;
Vergelijkbare producten zoals Sulfur-Containing Polymers: From Synthesis to Functional Materials
The Chemical Biology of Sulfur
This volume aims to provide an in-depth view of the complete biochemistry of sulfur with an emphasis on aspects not covered elsewhere;
Vergelijkbare producten zoals The Chemical Biology of Sulfur
Characterization, Properties and Applications
This volume on iron-sulfur proteins includes chapters that describe the initial discovery of iron-sulfur proteins in the 1960s to;
Vergelijkbare producten zoals Characterization, Properties and Applications
Transition Metals and Sulfur - A Strong Relationship for Life
Metal-Sulfur clusters play an essential role in living organisms through the unique character of sulfur-metal bonding. The new volume;
Vergelijkbare producten zoals Transition Metals and Sulfur - A Strong Relationship for Life
Microbial Sulfur Metabolism
This revealing book details recent developments in the study of the relationship between sulfur and the microbial agents that affect its;
Vergelijkbare producten zoals Microbial Sulfur Metabolism
Microbial Sulfur Metabolism
This revealing book details recent developments in the study of the relationship between sulfur and the microbial agents that affect its;
Vergelijkbare producten zoals Microbial Sulfur Metabolism
Rode sulfur
Den Haag, 1666. De oude kunst van de alchemie is aan het verdwijnen. Er woeden oorlogen met Engeland;...
Vergelijkbare producten zoals Rode sulfur
Rode sulfur
Den Haag, 1666. De oude kunst van de alchemie is aan het verdwijnen. Er woeden oorlogen met Engeland;...
Vergelijkbare producten zoals Rode sulfur
Rode sulfur
Den Haag, 1666. De oude kunst van de alchemie is aan het verdwijnen. Er woeden oorlogen met Engeland;...
Vergelijkbare producten zoals Rode sulfur
Biochemistry, Biosynthesis and Human Diseases
This volume on iron-sulfur proteins includes chapters that discuss how microbes, plants, and animals synthesize these complex prosthetic;
Vergelijkbare producten zoals Biochemistry, Biosynthesis and Human Diseases
The Sulfur Problem
Sulfur compounds contaminate many industrially important feedstocks and, on release to the atmosphere as sulfur oxides, can cause;
Vergelijkbare producten zoals The Sulfur Problem
Metal-Air and Metal-Sulfur Batteries
Metal-air and metal-sulfur batteries (MABs/MSBs) represent one of the most efficient-energy storage technologies, with high round trip;
Vergelijkbare producten zoals Metal-Air and Metal-Sulfur Batteries
Next-generation Batteries with Sulfur Cathodes
Next-Generation Batteries with Sulfur Cathodes provides a comprehensive review of a modern class of batteries with sulfur cathodes;
Vergelijkbare producten zoals Next-generation Batteries with Sulfur Cathodes
Sulfur Dioxide Sensors
Recent progress on the sensing and monitoring of sulfur dioxide in the environment is presented. Keywords: Sulfur Dioxide Toxicity;
Vergelijkbare producten zoals Sulfur Dioxide Sensors
Glutathione and Sulfur Amino Acids in Human Health and Disease
, disease prevention, and health promotion of glutathione and sulfur amino acids. Discussion deals with the complex relationship between GSH and;
Vergelijkbare producten zoals Glutathione and Sulfur Amino Acids in Human Health and Disease
Bioinspired Catalysis: Metal-Sulfur Complexes
This book provides an overview of bioinspired metal-sulfur catalysis by covering structures, activities and model complexes of enzymes;
Vergelijkbare producten zoals Bioinspired Catalysis: Metal-Sulfur Complexes
An Introduction To Organosulfur Chemistry
Sulfur chemistry is becoming increasingly important as the role of this element is explored in both biological and environmental fields;
Vergelijkbare producten zoals An Introduction To Organosulfur Chemistry
Advances in Plant Sulfur Research
Vergelijkbare producten zoals Advances in Plant Sulfur Research
Talking Loud . SULFUR CITY, CD
Vergelijkbare producten zoals Talking Loud . SULFUR CITY, CD
Einde inhoud
Geen pagina's meer om te laden'